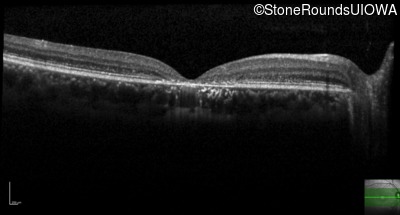
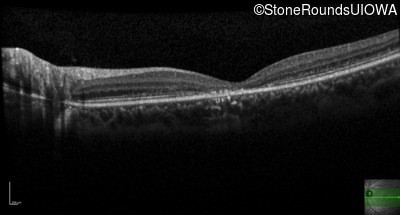
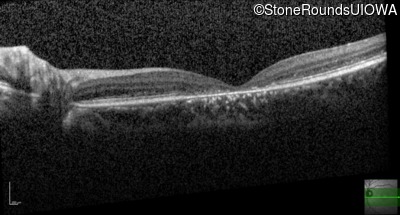
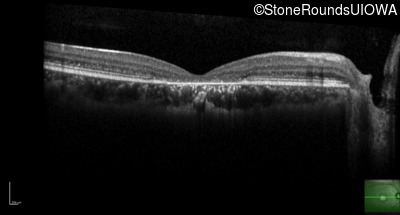
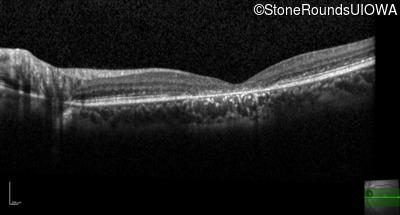

Case
SR226
Student Mode
AR Stargardt Disease (IIA)
Female
Female
Hidden
SR226
Student Mode
AR Stargardt Disease (IIA)
Female
Female
History
This 19 year old woman first noticed some reduction in visual acuity in the right eye more than the left at age 16. Her visual acuity had been previously normal.
| Color Vision: | 8/14 color plates OD, 10/14 OS. |
|---|---|
| Refraction OD: | -6.25 -1.00 x 160 |
| Refraction OS: | -5.50 -1.50 x 065 |
Teaching Points
The clinical features favoring the diagnosis of ABCA4-associated autosomal recessive Stargardt disease include: loss of acuity in the second decade, reduction in color discrimination and foveal photoreceptor loss on OCT.
| Age at visit: 19 years |
| Age at visit: 23 years |
Diagnosis & molecular findings
| Disease | Gene | Allele 1 variant(s) | Allele 2 variant(s) | Inheritance mode |
|---|---|---|---|---|
| AR Stargardt Disease | ABCA4 | Gly1961Glu GGA>GAA | Val1973 del1ggaG | AR |
Disease:
Gene:
Allele 1:
Gly1961Glu GGA>GAA
Allele 2:
Val1973 del1ggaG
Inheritance:
AR